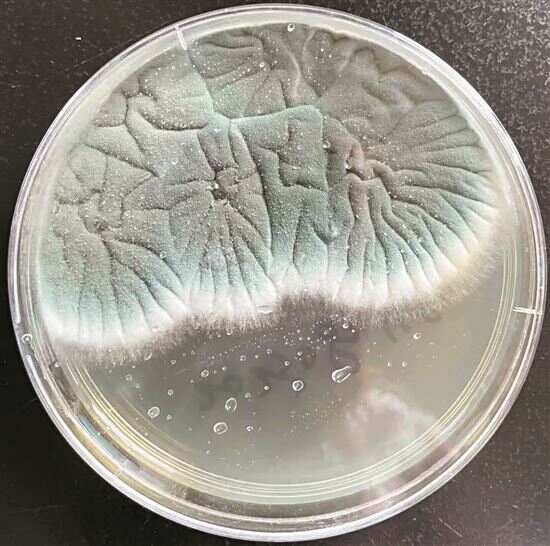

■一位市民的靴子上长了一层霉。 新快报记者 毛毛雨/摄
■从咳嗽患者肺泡灌洗液中分离出的烟曲霉菌。受访者供图
专家建议如果家中出现霉变,要注意做好个人防护
你够“潮”,天气比你更潮。近期广东气候反复,雨水充沛。根据预计,2024年“龙舟水”将从5月21日持续至6月20日。有市民反映,家中衣物晾晒多日依旧潮湿,衣服和人都要发霉了。
那么,身在广东的你,家中情况如何呢?我们又该如何与霉菌相处?专家建议人人都要做好个人防护,远离霉变的物品。
烦恼
枕头衣柜鞋靴“沦陷” 连墙壁也开满朵朵“霉花”
随着广东地区进入潮湿多雨的季节,许多家庭开始面临一个共同的问题——发霉。市民陈女士直呼“天气太潮湿,家里的衣服都要发霉了”。
当广东成为最“潮”的仔时,面临的首要问题就是衣物库存告急。潮湿的空气不仅让衣物难以晾干,还容易滋生霉菌,导致衣物出现霉斑、异味等问题。上班族阿颖就深受其扰,“每天的衣服穿了就是不敢洗,生怕洗了就长霉,宁可放着也要让它保持干燥。”
的确,前段时间的“回南天”里,衣服难干,放晴没几天又迎上雨季,衣服总是湿漉漉的,无法完全干透。这也让市民阿然感到十分头疼,不仅担心衣物发霉,还担心长期穿着潮湿的衣物对健康造成影响,“熬过这个雨季大概就好了。”阿然无奈道。
但是,阿颖表示自己也有“绝招”——“穿衣服新三天,旧三天,挑挑拣拣又三天,”阿颖不好意思地笑道,“这也是没办法的办法了。”
除了衣物,不少来自广东的网友还晒出了自家的枕头、被褥、衣柜、鞋靴、碗筷、棉签都不出意料地发霉变色,乃至客厅墙壁都开满了朵朵“霉花”,属实让人苦恼。
市民小璐“五一”出去旅游,离家三天归来也“中招”了,映入眼帘的就是自己的枕头、被子的大片霉点,看到的瞬间觉得“心态崩了”;网友肉松在床头摆了半年的拼图,近日才发现变成了霉菌的“培养皿”,背面木板长满霉斑,“看一次鸡皮疙瘩冒一次”;小钟展示了自己也未能幸免的靴子,正无奈该如何处理。
刚刚收拾完长霉衣柜的市民大吉也有话要说,“我的衣柜里放的全是大衣羽绒服,甚至在思考要不要连衣柜一起扔掉,收拾完以后感觉呼吸道里全是霉菌,浑身上下都不舒服。”
家住广东的阿然发现自家墙壁有一小块发霉,想着周末再处理,没想到霉菌越长越多,直到连成一片,最烦恼的是擦了以后下雨又会卷土重来。“毫不夸张地说,在这个季节里,地上永远是一层未干的水汽,楼道是湿润的墙壁,还有不断生长、清除不完的绿色霉菌。”阿然说。对于种种情况,他戏谑唯一的解决方式就是“离开广东”。
科普
医学专家郭卫真建议——
一旦发现衣物发霉 首先做好个人防护
近日,新快报记者就衣物发霉科普话题,专访了广州中医药大学第一附属医院检验科副主任技师郭卫真,她从事临床检验工作多年,专长为微生物学检验。
什么情况下,衣物容易发霉?郭卫真说,“当室温达到20°C-30°C,湿度达到60%以上,特别在南方的回南天,漂浮在空间的丝状真菌孢子遇到潮湿衣物,就会在衣物上以菌落形式生长,使衣物形成大小不一的霉点,广州话俗称‘发霉’。”
“为了防止衣物发霉,市民在回南天时,最好把家里的门窗关上,把空调抽湿打开,保持家里环境干爽,如此,便可有效预防家里衣物发霉。”她说,在回南天到来前,建议市民提前把需要收纳的衣服、被子在太阳下晒干,或用烘干机烘干,用密闭的真空袋装好,也可以有效防止发霉。她建议人人都要做好个人防护,远离霉变的物品。
她提到,霉菌是一种真菌。家具、墙壁上霉点形成与衣物相同,都是由丝状真菌生长引起的。常见的丝状真菌有曲霉菌、青霉菌等,以曲霉菌最常见。曲霉菌是最常引起人体感染的条件致病性霉菌之一。曲霉菌又以烟曲霉菌、黄曲霉菌、黑曲霉菌多见。
“真菌是一种条件致病菌,穿了发霉的衣物,身上有伤口或免疫力低下的人群,就容易被真菌感染,引起皮肤、鼻窦、眼、耳、支气管、肺、中枢神经系统等真菌病。”郭卫真说,广州湿润多雨的气候,一旦发现衣物发霉,建议首先做好个人防护,比如戴上口罩、一次性帽子、手套,穿上可浸泡消毒剂的衣服,再用合适浓度(最好选用75%浓度)的酒精喷洒发霉地方,5分钟后,需要按不同材质衣物,选用适合的方法对衣物进行浸泡洗涤。一般来讲,酒精喷洒5分钟后,再用消毒液浸泡衣物30分钟,然后选用含有消毒成份的洗衣液、洗衣粉或肥皂液进行清洗,洗干净的衣物最好在太阳下晒干,或用烘干机烘干。
郭卫真建议市民在家里常备75%酒精和含氯消毒液,一旦发现有物品发霉,可及时处理。她特别提醒道,“在处理发霉的衣物时,直接用手拍打或用口吹衣物发霉的地方,都是错误的做法,因为每株丝状真菌顶部都有成千上万的孢子,这些孢子只要轻轻动动,就会到处飘洒,污染空间。”
在日常生活中有何小妙招?她说,广州人常用的樟脑丸子挺好用,除此之外,她还喜欢使用烘干机来烘干衣服。
郭卫真最后提到,对于霉菌,我们不能乱棍打死。因为除了弊端,霉菌对人类还有不少用途,比如从点青霉、黄青霉等青霉提取的青霉素,挽救了无数被细菌感染患者的生命。
天气
新一波“龙舟水”已来临 时段为5月21日至6月20日
每年前汛期(4—6月)有一段降水较为集中的时期,经常隔三差五就会下一场滂沱大雨,由于时值端午节龙舟竞渡,民间形象地称之为“龙舟水”。
“龙舟水”雨量大、雨势强,是汛期中的“战斗机”。根据广东气象部门预计,今年的“龙舟水”时段为5月21日至6月20日。事实上,在5月19日至21日,已出现第一场“龙舟水”天气。
对于接连不断的滂沱大雨,阿然不禁发出灵魂拷问,“太阳到底何时营业,让我把衣服洗完晒干?”广东气象部门表示,“龙舟水”统计期内尽管降水相对集中,但并不意味着天天都下暴雨,请广大市民留意气象部门发布的预报预警信息。
攻略
总结各方经验 送你防潮攻略
适时关窗:
早晨和晚上空气湿度大,建议窗户紧闭。
空调除湿:
用除湿器或者空调,抽取空气中的水分。
报纸防霉:
旧报纸贴在玻璃、地面、壁柜,可除湿。
洗衣粉防潮:
洗衣粉放置盒中,吸水结块后可洗衣。
家电防潮:
家电每天通电使用,利用自身产热去湿。
吹风筒吹干:
电吹风冷风吹上十五分钟,衣服速干。
■采写:新快报记者 陈慕媛 毛毛雨

